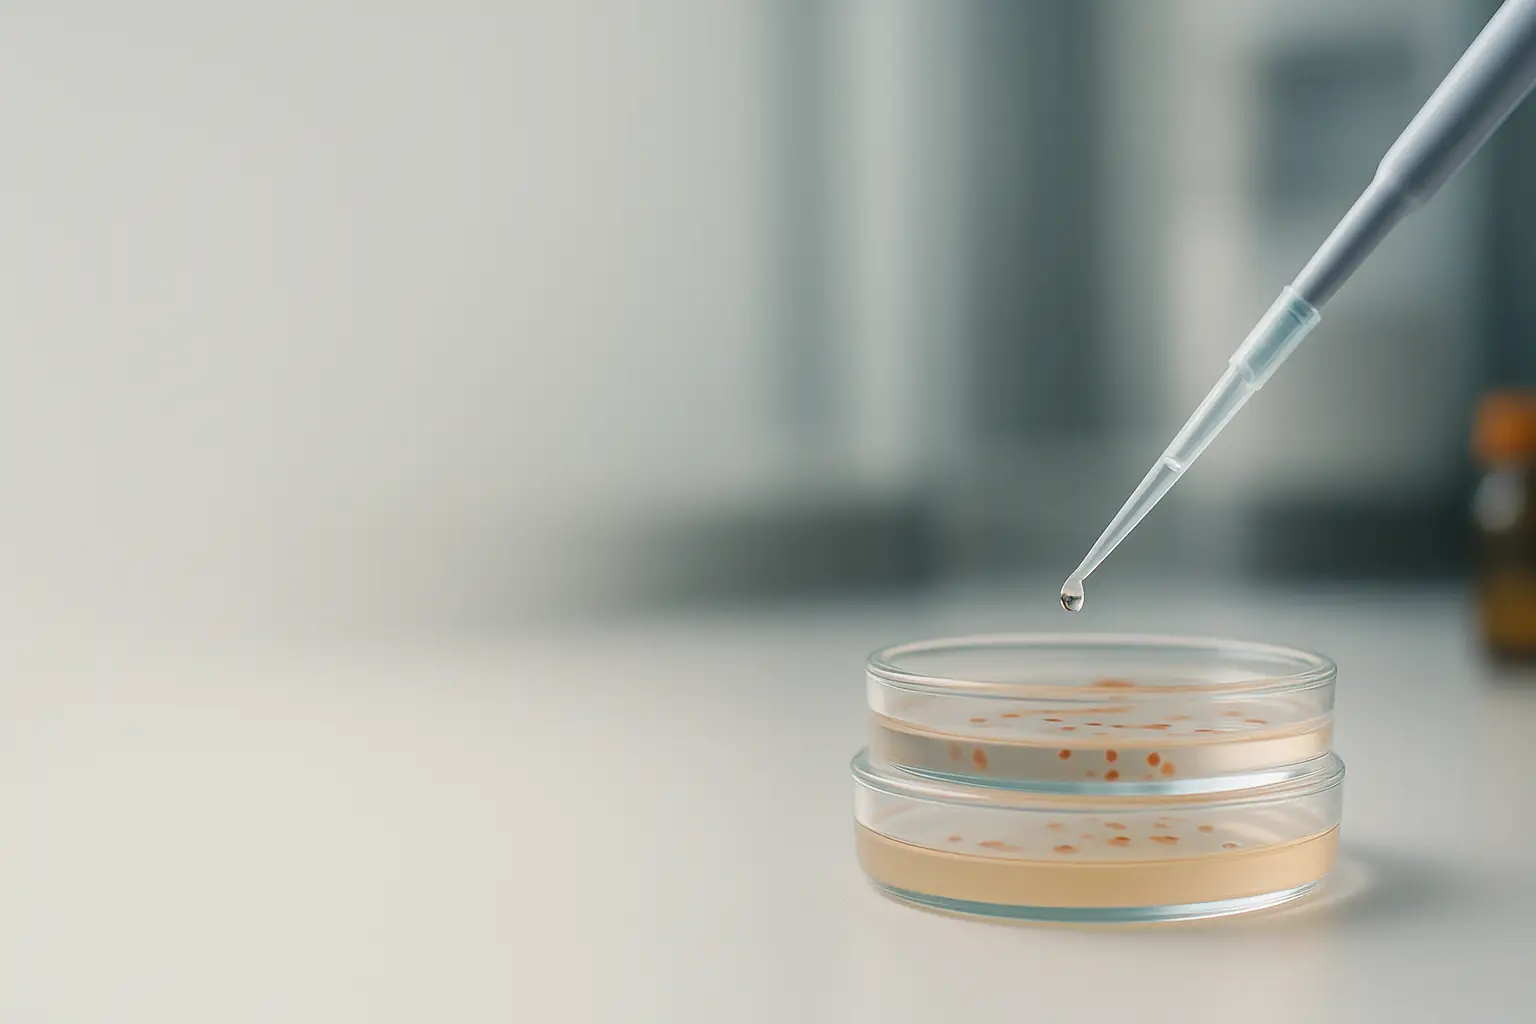
Proficiency testing provider | microbiology PT scheme

News & Updates
Stay updated with ILT’s latest programs, initiatives, and resources.
Here you will find news about new testing areas, updates on our services, and practical information on program procedures
Interlaboratory Cybersecurity Program for IoT Devices

Interlaboratory Cybersecurity Program for IoT Devices ILT‑U‑3748 · Determination of cybersecurity requirements per EN 18031 The rapid digitalization and use of Internet‑connected IoT devices significantly increase exposure to cybersecurity risks.To help manufacturers, laboratories, and conformity assessment bodies prepare for these new requirements, ILT has developed the interlaboratory program ILT‑U‑3748, focused on verifying cybersecurity requirements according…
How ILT Microbiology Proficiency Programs Work
How ILT Microbiology Proficiency Programs Work Our microbiology programs are designed to combine international quality standards with practical methodology adapted to the needs of laboratories. Each kit contains five (5) lyophilized strains of Escherichia coli (enumerated/CFU).With these strains, laboratories can perform five independent tests, reporting their results for interlaboratory comparison. In addition, the program allows…
Environmental Consulting Services

Our consulting division offers a wide range of environmental solutions designed to support organizations in meeting regulatory requirements, minimizing risks, and enhancing their sustainability performance. Services offered include: Environmental Studies Environmental Impact Assessments (EIA) Environmental Compliance Reports (IAC) Environmental Management Plans (EMP) Environmental Audits Regulatory & Legal Advisory Calculation and verification of carbon footprint (organizational…
Personalized Pre-Verification Process

Personalized Pre-Verification Process A tailored assessment to evaluate your current methodology, data sources, and assumptions, ensuring your organization is ready for a complete and verifiable environmental footprint measurement. Objective To assess the client’s current methodology and its readiness to progress toward a complete and verifiable measurement. Scope Includes Review based on the desired footprint type…